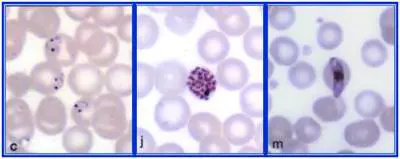
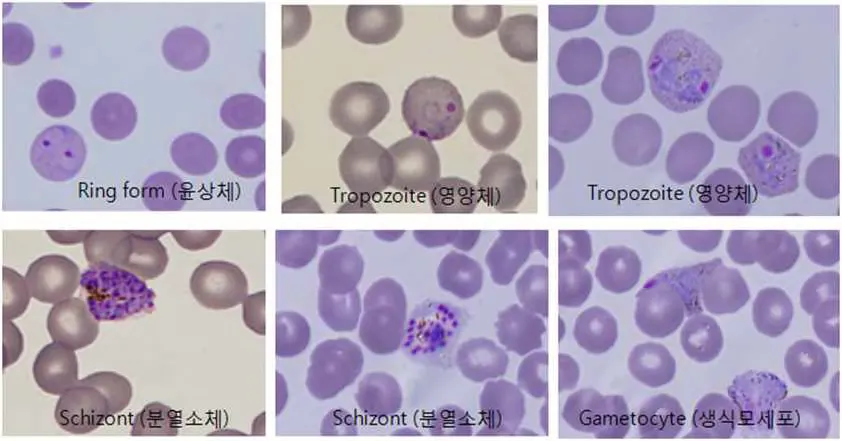

A. 서론
•
말라리아는 anopheles mosquito에 의해 전염되는 열대/아열대 지역의 원충질환
(사람이 중간숙주, 모기가 최종숙주)
•
총 5종으로 종마다 임상양상, 잠복기 예후의 차이 존재
•
우리나라 토착형은 삼일열(vivax)만 존재하고 열대열(falciparum)보다 중증도가 낮고 잠복기가 길다
B. 역학
•
국내에서는 1953년 법정 감염병 지정 후 퇴치 사업으로 1984년 근절되었다.
1993년 휴전선 인근 경기 북부 지역 군 장병에서 삼일열 말라리아 다시 발생하기 시작하여 증가하다가 2010년부터는 감소 추세이다.
B1. 국내 삼일열 말라리아
(1) 발생 지역
: 경기 파주/경기 김포/경기 연천/인천 강화/인천 서구/강원 철원
(2) 잠복기
: 단기 잠복기 (12~18일), 장기 잠복기 (6~12개월), 1.7:1로 단기 잠복기 환자가 많음.
(3) 발생 시기
① 6~9월 사이에 집중적으로 발생
② 4~5월에 발생하는 환자는 1년 전 감염된 후 장기 잠복기를 거쳐 발생한 경우.
B2. 해외 유입 말라리아
•
60명/년 정도로 20~40대 젊은 연령층에서 많이 발생
•
열대열이 가장 흔하고, 그 다음 삼일열, 나머지는 드물다
•
열대열은 대부분 아프리카에서, 삼일열은 대부분 동남아시아에서 감염
•
잠복기 : 9~14일 (열대열)
C. 약제 내성
1.
국내 발생 삼일열 말라리아 : Chloroquine 내성을 보이는 열원충은 없음.(TOC).
2.
열대열 말라리아 : 대부분의 국가에서 chloroquine 내성이 만연함.
다른 여러 항말라리아약에 대해서도 내성률이 높아지는 추세.
D. 증상
1.
가장 특징적인 임상 증상은 주기성을 갖는 열.
2.
삼일열, 난형열 말라리아는 48시간 주기, 사일열 말라리아는 72시간 주기, 열대열 말라리아는 매일 발생. 그러나 질병 발생 초기에는 이러한 주기성 없이 매일 열남.
3.
열대열 말라리아 : 중증 진행 시 황달, 응고장애, 간/신부전, 쇼크 가능
D1. 혈액검사(Lab) 소견
•
말초혈액도말(Peripheral blood smear): 가장 정확한 진단법으로, Thick smear에서는 원충 검출 여부를, Thin smear에서는 Plasmodium 종(species)을 확인함.
•
혈소판감소증(Thrombocytopenia): 흔한 소견으로, 대부분 경증~중등도 감소를 보임.
•
빈혈(Anemia): 용혈로 인해 나타남.
•
백혈구감소증(Leukopenia) 및 상대적 림프구증(Relative lymphocytosis) 가능.
•
LDH 상승 및 빌리루빈 증가: 용혈로 인한 이차 변화.
•
AST, ALT 상승: 간세포 손상 소견.
•
CRP, Procalcitonin 상승: 염증 반응 반영.
•
Rapid Diagnostic Test (RDT): 항원검출검사로 빠른 선별 가능.
D2. 복부 CT 소견
•
비장비대(Splenomegaly): 가장 흔한 CT 소견으로, P. vivax 감염군에서 현저히 큰 비장 길이를 보임.
•
비장 저음영 병변(Splenic focal low attenuation): 국소 허혈 혹은 괴사 부위.
•
자발적 비장 파열(Spontaneous splenic rupture) 가능성.
•
간비대(Hepatomegaly): 동반 가능하며, 간실질의 경미한 저음영이나 혈류 변화가 관찰될 수 있음.
•
비장경색(Splenic infarction): CT상 국소 저음영, 삼각형 모양의 피질부 결손으로 보이며, 혈액 내 Plasmodium 감염 시 혈전 형성에 의해 발생.
•
간 및 비장의 조영증강 불균질(Heterogeneous enhancement): 국소 순환장애 반영.
•
복수(Ascites): 드물지만 중증 감염 시 관찰됨.
혈액검사에서는 혈소판감소, 용혈성 빈혈, 간기능 이상, 빌리루빈 상승, CT에서는 비장비대·비장저음영·비장경색 또는 파열이 말라리아의 특징적 패턴을 구성.
E. 진단
•
말초혈액도말표본이 가장 중요. 후층도말표본(thick smear)과 박층도말표본(thin smear)을 모두 시행.
Malaria smear
•
별도의 시설이 필요하나 PCR은 가장 정확하고, 혈액내 원충이 극소량이라도 진단이 가능.
말라리아 5종 감별 / 동시 감염 감별 가능.
•
신속진단키트는 현미경 검사의 보조적인 방법으로 사용, 위양성 가능
Malaria Ag(f/Pan) rapid test
•
Smear 혹은 PCR로 확진 (신속진단키트는 확진 못함)
* 열대열 원충 (P. falciparum)
* 삼일열 원충 (P. vivax)
F. 화학적 예방과 치료
•
경구투여가 기본 원칙 (중증 말라리아의 경우 비경구투여)
•
화학적 예방을 시행한 사람이 해외유입 감염된 경우, 다른 성분으로 치료
•
말라리아의 종류나 내성여부가 불확실한 경우 약제내성 열대열로 간주하고 치료
•
열대열은 갑자기 합병증이 진행 가능, 초기 48시간 이상 입원하여 치료반응 확인
(이틀 후 기생충 혈중농도가 치료 시작 지점의 25% 아래가 안되면 내성 의심)
F1. 말라리아 표준치료
•
Chloroquine은 혈액 내에 있는 열원충 박명
•
Primaquine은 간에 있는 수면소체 (Hypnozoite) 박멸 목적 (P.vivax, P.ovae에만 있음)
(1) Chloroquine sensitive P.vivax or P.ovae
•
Chloroquine (Haloxin) 3일 + Primaquine (Vivaquine) 14일
•
Hydroxychloroquine 4/3곱해서 용량변환 (60 kg 의 경우 800-800-400)
•
HCQ 투약 종료 후 Primaquine 1T 1일 1회로 총 14일, 70 kg 이상은 2T 처방 (0.25 ㅡㅎ/ㅏㅎ)
•
Day 1 : 10 mg/kg (HALOXIN TAB 200mg 3T + 100 mg Tab 0.5T) or 800 mg
•
Day 2 : 10 mg/kg (HALOXIN TAB 200mg 3T + 100 mg Tab 0.5T) or 800 mg
•
Day 3 : 5mg base/kg or 400 mg
(2) Chloroquine resistance P.vivax or P.ovae
•
Mefloquine (Lariam) 3일 + Primaquine (Vivaquine) 14일
•
Atovaquone/proguanil (Malarone) 3일 + Primaquine (Vivaquine) 14일
•
Artesunate/pyronaridine (원내 없음) 3일 + Primaquine (Vivaquine) 14일
(Falciparum 포함 나머지는 이 regimen에서 primaquine만 제외)
(3) 중증 말라리아
•
Artesunate IV
(4) 임산부
•
Chloroquine 사용 가능
•
Primaquine, atovaquone/proguanil, artesunate/pyronaridine 사용 불가
: Mefloquine은 사용 가능하나 임신 초기에는 risk-benefit 따져서 투약
F2. 말라리아 화학적 예방
(1) 클로로퀸 내성 없는 삼일열 지역
•
Chloroquine (Haloxin) 을 여행 1~2주 전부터 여행 4주 후까지 매 1주마다 복용
(2) 클로로퀸 내성 있는 삼일열/열대열 지역 중 메플로퀸 내성 없는 지역
•
Mefloquine (Lariam) 을 여행 1~2주 전부터 여행 4주 후까지 매 1주마다 복용
(3) 다제내성(클로로퀸, 메플로퀸 내성) 지역
•
Atovaquone/proguanil을 여행 1~2일 전부터 여행 1주 후까지 매일 복용
(4) 모든 말라리아 지역
•
Doxycycline을 여행 1~2일 전부터 여행 4주 후까지 매일 복용하는 것은 모든 말라리아 지역에서
사용 가능 (다제내성 지역도 가능)
•
Tintinalli 9th의 주요 내용
1.
P. vivax 와 P. ovale 감염은 간내 형태의 하나로 수면소체(hypnozoites)가 있으며,
이것은 혈액으로 배출되지 않고 간내 잠복하여 수개월~수년 후 임상적으로 재발가능
2.
많이 의심되는 환자의 경우, 박층도말표본(thin blood film)에서 parasitemia를 발견하지 못했다
고 해도
치료 중단의 적응증이 되지는 않는다.
(삼일열 말라리아의 경우 혈액 내 개체수가 적어 박층도말에서는 발견되지 않는 경우도 있다.
그래서 후층도말표본(thick blood film)도 같이 시행하는 것이다.)
3.
중증 말라리아 시에는 검사실 확진을 기다리며 치료를 지연해서는 안된다